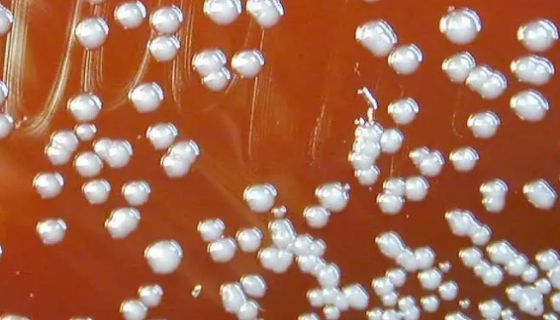
洋葱伯克霍尔德氏菌复合物的鉴定方法及研究进展！

流感嗜血杆菌的症状诊断及预防与治疗!
流感嗜血杆菌是一种没有运动力的革兰氏阴性杆菌。它是于1892...

胞内分枝杆菌的生长特性与外部描述及诊断治疗!
胞内分枝杆菌,短至长杆菌。新生长暂时丝状,最后变为球杆菌。蛋...

化脓性链球菌的感染特点与生化反应及临床意义!
化脓性链球菌广泛存在于自然界中、人体表面以及与外界相通的腔道...

幽门螺杆菌的健康危害与临床表现及防治方法!
幽门螺杆菌是一种螺旋形、微厌氧、对生长条件要求十分苛刻的细菌...

军团菌——隐藏在空调里的“杀手”!
军团菌(Legionella)是一种广泛存在于自然界中的机会...

犬小孢子菌的培养特性与鉴别要点及临床意义!
犬小孢子菌是较常见的致病性真菌,由Gruby在1843年首次...
洋葱伯克霍尔德氏菌复合物的鉴定方法及研究进展!
洋葱伯克霍尔德氏菌是革兰氏阴性杆状细胞,具有多根极端鞭毛,在...

炭疽芽孢杆菌的特征特性与实验室检查!
炭疽芽孢杆菌(Bacillus anthrax)俗称炭疽杆菌...

六月钜惠!买特殊细胞赠送定制培养基
Biobw真情回馈——购特殊细胞,送定制培养基!